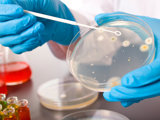

Blogs
Are you interested in writing a blog on healthcare improvement? Get in touch with us to suggest ideas for future content.

29 April 2024
Megan Leach: Navigating the journey of becoming a carer
As I reflect on my journey as a carer, I am driven by a fervent desire to effect meaningful change within our healthcare system.